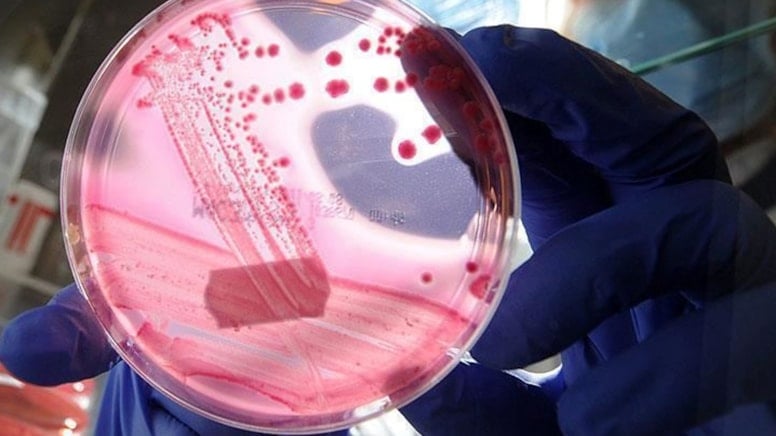
DSÖ'den kanser açıklaması: Dünya genelindeki vakaların 4'te 1'i önlenebilir

DSÖ, Uluslararası Kanser Araştırma Ajansının (IARC) da katkılarıyla 4 Şubat Dünya Kanser Günü dolayısıyla rapor yayımladı.
Raporda, dünya genelindeki kanser vakalarının 4'te 1'inin önlenebileceği vurgulandı.
Tütün, alkol, fiziksel hareketsizlik, hava kirliliği, ultraviyole radyasyon ve enfeksiyonlar dahil olmak üzere 30 önlenebilir nedenin incelendiği raporda, "2022'deki tüm yeni kanser vakalarının yüzde 37'sinin yani yaklaşık 7,1 milyon vakanın önlenebilir nedenlerle bağlantılı olduğu tahmin ediliyor. Bulgular, küresel kanser yükünü azaltmada önlemenin büyük potansiyelini vurguluyor." değerlendirmesinde bulundu.
185 ÜLKEDEN VERİ TOPLANDI
Raporda, 185 ülke ve 36 kanser türünden elde edilen verilere göre, tütünün, küresel olarak tüm yeni kanser vakalarının yüzde 15'inden sorumlu ve önlenebilir kanserin başlıca nedeni olduğu belirtilerek, kansere yüzde 10 ile enfeksiyonlar ve yüzde 3 ile alkol tüketiminin neden olduğu kaydedildi.
Akciğer, mide ve rahim ağzı kanserinin küresel olarak önlenebilir kanser vakalarının neredeyse yarısını oluşturduğuna işaret edilen raporda, akciğer kanserinin öncelikle sigara ve hava kirliliğiyle, mide kanserinin büyük ölçüde helikobakter pilori enfeksiyonuyla, rahim ağzı kanserinin de genellikle İnsan Papilloma Virüsü (HPV) ile ilişkilendirildiği bildirildi.
ERKEKLERDE SİGARA VE ALKOL BELİRLEYİCİ
Raporda, önlenebilir kanser vakalarının kadınlara göre erkeklerde önemli ölçüde daha yüksek olduğu vurgulanarak, yeni kanser vakalarının yüzde 45'inin erkeklerde, yüzde 30'unun ise kadınlarda görüldüğü belirtildi.
"Erkeklerde tüm yeni kanser vakalarının tahmini yüzde 23'ü sigaradan, yüzde 9'u enfeksiyonlardan ve yüzde 4'ü alkolden kaynaklandı." ifadesi kullanılan raporda, kadınlarda ise küresel olarak tüm yeni kanser vakalarının yüzde 11'inin enfeksiyonlardan, yüzde 6'sının sigaradan ve yüzde 3'ünün yüksek vücut kitle indeksinden kaynaklandığına işaret edildi.
Raporda, "Bulgular, tütüne dair önlemler, alkol düzenlemesi, HPV ve hepatit B gibi kansere neden olan enfeksiyonlara karşı aşılama, iyileştirilmiş hava kalitesi, daha güvenli iş yerleri ve daha sağlıklı gıda ile fiziksel aktivite ortamlarını içeren, duruma özgü önleme stratejilerine duyulan ihtiyacın altını çiziyor." ifadesine yer verildi.
ERKEKLERDE EN YÜKSEK ÖNLENEBİLİR KANSER ORANI YÜZDE 57 İLE DOĞU ASYA'DA
Önlenebilir kanser oranlarının, bölgeler arasında büyük farklılıklar gösterdiği bildirilen raporda, kadınlarda önlenebilir kanser oranlarının Kuzey Afrika ve Batı Asya'da yüzde 24'ten Sahra Altı Afrika'da yüzde 38'e kadar değişiklik gösterdiği belirtildi.
Raporda, erkeklerde en yüksek oranın yüzde 57 ile Doğu Asya'da, en düşük oranın ise yüzde 28 ile Latin Amerika ve Karayipler'de gözlemlendiği kaydedildi.
Raporda, bu durumun, davranışsal, çevresel, mesleki ve bulaşıcı risk faktörlerine maruz kalmanın yanı sıra sosyoekonomik kalkınma, ulusal önleme politikaları ve sağlık sistemi kapasitesindeki farklılıkları yansıttığına işaret edildi.
"NE KADARININ ÖNLEYEBİLECEĞİMİZ NEDENLERDEN KAYNAKLANDIĞINI GÖSTEREN İLK KÜRESEL ANALİZ"
Raporda görüşlerine yer verilen çalışmanın yazarı ve DSÖ Kanser Kontrolü Ekip Lideri Andre Ilbawi, "Rapor, kanser riskinin ne kadarının önleyebileceğimiz nedenlerden kaynaklandığını gösteren ilk küresel analiz." değerlendirmesinde bulundu.
Ilbawi, ülkeler ve nüfus grupları genelindeki kalıpları inceleyerek, hükümetlere ve bireylere birçok kanser vakasının önlenmesine yardımcı olacak daha spesifik bilgiler sağlayabileceklerine değindi.
IARC Kanser Gözetim Birimi Başkan Yardımcısı Isabelle Soerjomataram ise raporun dönüm noktası niteliğinde olduğunun altını çizdi.
Soerjomataram, "(Rapor) İlk kez davranışsal, çevresel ve mesleki risklerin yanı sıra kanserin bulaşıcı nedenlerini de içeren, dünya çapında önlenebilir kanserin kapsamlı bir değerlendirmesidir. Bu önlenebilir nedenlere çözüm bulmak, küresel kanser yükünü azaltmak için en güçlü fırsatlardan birini temsil etmektedir." ifadelerini kullandı.